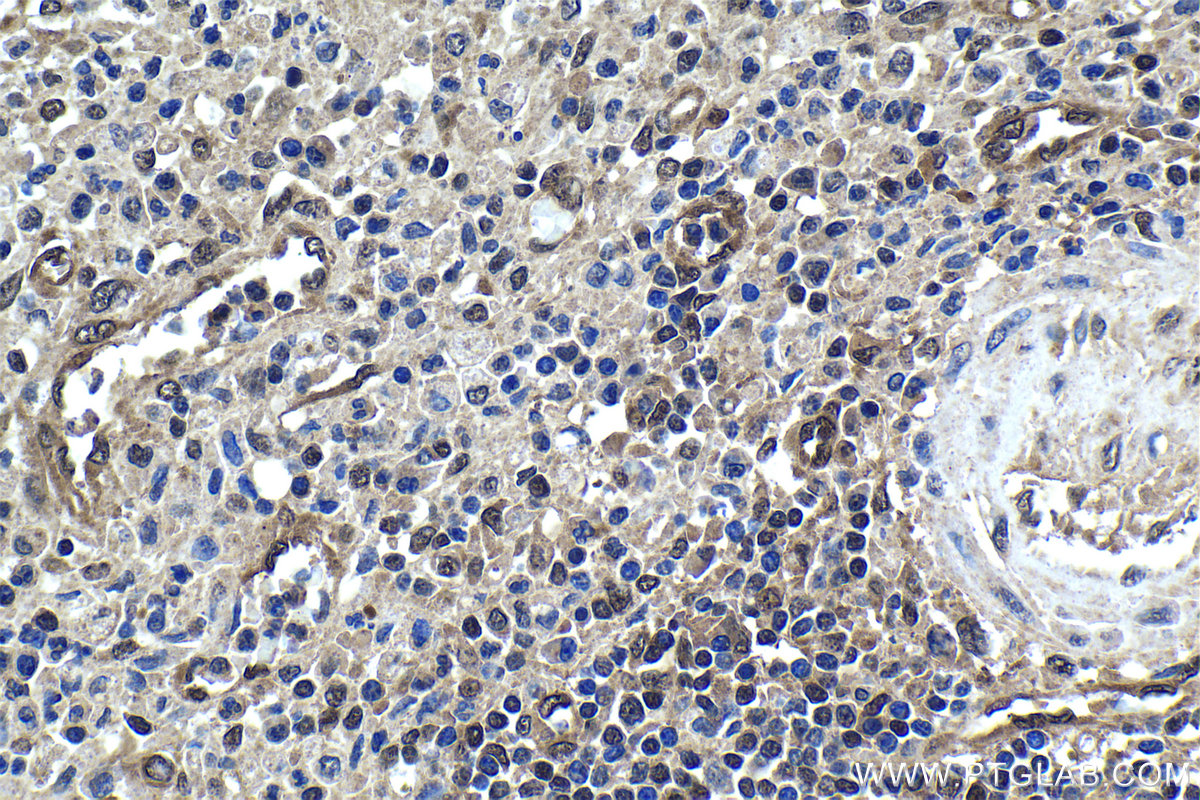

验证数据展示
产品信息
60246-1-PBS targets 4EBP1 in WB, IHC, IF/ICC, ELISA applications and shows reactivity with human, pig samples.
| 经测试应用 | WB, IHC, IF/ICC, ELISA Application Description |
| 经测试反应性 | human, pig |
| 免疫原 |
CatNo: Ag18985 Product name: Recombinant human 4EBP1 protein Source: e coli.-derived, PET28a Tag: 6*His Domain: 1-118 aa of BC004459 Sequence: MSGGSSCSQTPSRAIPATRRVVLGDGVQLPPGDYSTTPGGTLFSTTPGGTRIIYDRKFLMECRNSPVTKTPPRDLPTIPGVTSPSSDEPPMEASQSHLRNSPEDKRAGGEESQFEMDI 种属同源性预测 |
| 宿主/亚型 | Mouse / IgG2b |
| 抗体类别 | Monoclonal |
| 产品类型 | Antibody |
| 全称 | eukaryotic translation initiation factor 4E binding protein 1 |
| 别名 | EIF4EBP1, eIF4E-binding protein 1, eIF4E binding protein 1, BP 1, 4E-BP1 |
| 计算分子量 | 118 aa, 12 kDa |
| 观测分子量 | 15-24 kDa |
| GenBank蛋白编号 | BC004459 |
| 基因名称 | EIF4EBP1 |
| Gene ID (NCBI) | 1978 |
| RRID | AB_2881368 |
| 偶联类型 | Unconjugated |
| 形式 | Liquid |
| 纯化方式 | Protein A purification |
| UNIPROT ID | Q13541 |
| 储存缓冲液 | PBS only, pH 7.3. |
| 储存条件 | Store at -80°C. The product is shipped with ice packs. Upon receipt, store it immediately at -80°C |
背景介绍
Eukaryotic translation initiation factor 4E-binding protein 1(4EBP1), is a member of 4EBPs family, which regulate the translation of a subset of mRNA by competing with eIF4G for binding to eIF4E, thus preventing the assembly of the eIF4F complex. The eIF4F facilitates the recruitment of other translation initiation factors to form the complex and then initiates cap-dependent translation.4EBP1 also mediates the regulation of protein translation by growth factors, hormones and other stimuli that signal through the MAP kinase and mTORC1 pathways. There are three forms of 4EBP1, alpha, beta and gamma.typical pattern seen on Western blots for phosphorylated heat-acid stabled protein 4EBP1 from rat gastrocnemius muscle. Three distinct bands are noted, with the most rapidly migrating band having an apparent molecular mass of ; 20 kDa and the slowest migrating band of; 24 kDa. The 3 bands are designated by convention asalpha, beta and gamma. (PMID: 10913029)